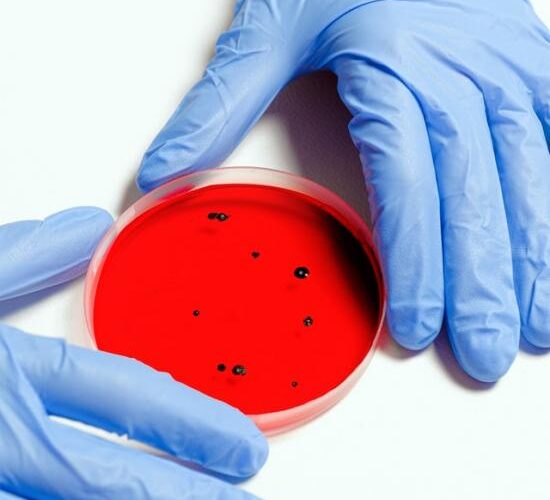
scientist-holding-petri-dish-3786247

Median 5-Day Incubation Period for COVID-19
The median incubation period for coronavirus disease 2019 (COVID-19) is approximately 5 days, according to study results published in medRxiv.
The first case of COVID-19 was identified in China in December 2019; however, there are limited data on the incubation period for COVID-19, which has estimated the range to be between 2 days and 14 days. The incubation period for COVID-19 has important implications for public health activities, including active monitoring, surveillance, modeling, and disease control. The objective of this study was to gain a better understanding of the COVID-19 incubation period and estimate its length as well as to examine its implications on public health.
Therefore, researchers performed a pooled analysis of data on 181 patients outside Hubei, China, with confirmed COVID-19. English and Chinese news reports and press releases from 50 provinces, regions, and countries were utilized, and data including cases reported between January 4 and February 24, 2020, were used in the analysis. Researchers recorded the dates and times of possible disease exposure for each patient (either via travel history or under the assumption of the maximum possible interval of exposure to an infected person) as well as symptom onset, fever onset, and case detection. Incubation time was estimated using a parametric accelerated failure time model under the assumption that incubation time followed log-normal distribution similar to that observed in other acute respiratory viral infections.







